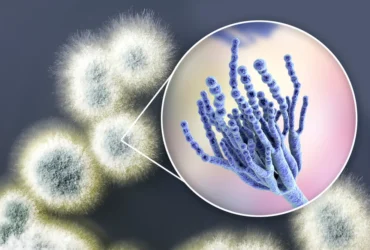
Mold Spore Levels Explained

Ultimate Mold Crew Inc. offers Mold Removal in Toronto by WSIB & IICR Certified specialists. We provide fast same-day toxic mold removal, remediation, inspection & testing across Toronto & GTA to ensure Safe Air and Healthy Home environment. Call ☎️ 647-985-2739 for free mold inspection now.
FREE MOLD INSPECTION VIA VIDEO CALL
Book your appointment today!
Safe & Effective Mold Removal Services Toronto
Are you noticing black mold growth in your home? Mold growth is a common problem in Toronto homes and businesses, especially in basements, attics, and areas affected by moisture and poor ventilation. Our mold removal services in Toronto are designed to safely eliminate mold at the source while preventing future growth. Spring season in Toronto creates the perfect conditions for mold to return, and this is often when hidden mold problems start showing up.
Our mold removal professionals in Toronto uses industry-approved mold removal methods, including HEPA filtration, containment systems, and negative air pressure. Whether you’re dealing with black mold, hidden mold behind walls, or widespread contamination, our team ensures complete and safe mold removal.
At “The Ultimate Mold Crew”, customer satisfaction is paramount. We specialize in residential and commercial mold removal, indoor air quality testing & water damage restoration. Our process focuses not just on removing mold, but on identifying and correcting the underlying cause to prevent recurrence.
Having a Mold Emergency? UMC Offers Same-Day Mold Removal Services in Toronto GTA.
Call ☎️647-985-2739 For 24/7 Emergency Services
What Customers Say About Us?
EXCELLENT Based on 68 reviews Posted on Guy DAmbrosioTrustindex verifies that the original source of the review is Google. So glade I came across your link… I spoke with Kay . Kay listened to our concerns and our budget as a long term care facility . Kay was Kay and responded with a service that was exactly what we needed . Kay the. Set up a time that was kay-veant for us … the follow day Matt , I said Matt came by . He looked at your 8 spas and was able to identify Mold as surface Mold . It was a relief and made recommendations in his report … Matt thank you for your knowledge and Kay thank you for responding to our needs in an affordable manor . Cheers !Posted on Leeza MisropTrustindex verifies that the original source of the review is Google. Priya was amazing! Answered all my questions regarding my concerns.Posted on B ETrustindex verifies that the original source of the review is Google. Fast, professional and fair price. We got several quotes, they are not the cheapest nor the most expensive, but from initial contact to end of job, they demonstrated themselves to be very well-organized, professional and excellent in what they do. I have no hesitation to use them again, or to recommend them to anyone who can make use of their service. Very happy to have them helped us!Posted on Kim VoakesTrustindex verifies that the original source of the review is Google. Everyone we dealt with was super nice, prompt, and most importantly did a great job. They got in as fast as possible to help us out and are clearly professionals at this. Also very fair pricing. No one wants to deal with mold issues, but if we need to in the future I would definitely reach out to the Ultimate Mold Crew. Thank you guys!Posted on Matthew PatrickTrustindex verifies that the original source of the review is Google. The team was professional and efficient. Everything was handled smoothly online, and they made sure every detail was perfect. Highly recommend!Posted on Wayne McKeeTrustindex verifies that the original source of the review is Google. The crew just finished and the results were awesome. The service was amazing, I was able to get everything done electronically since I am in new brunswick with pictures and full descriptions. Everyone treated the house as if it was their own. One of the best companies I've dealt with.Posted on Sen YangTrustindex verifies that the original source of the review is Google. Very professional and genuinely good people that look out for their customers.Posted on Monica SivinTrustindex verifies that the original source of the review is Google. So thankful for UMC and their team! Dado was an amazing help with our attic! He was professional, clean and quick. He communicated every step he needed to take and took lots of photos for us to see his progress. Couldn’t be happier with the service. We will definitely be using Ultimate Mold Crew again in the future! Thanks guys!Posted on Rick MenaryTrustindex verifies that the original source of the review is Google. Have used their service on 2 properties. They are quick , they are thorough and professional and have great results at a reasonable price.
What We do?
Mold Testing & Inspection
Mold Removal
COVID-19 Cleaning & Disinfection
Air Quality Testing
Certified Mold Remediation Specialists in Toronto
Ultimate Mold Crew specializes in professional mold remediation, mold inspection, and black mold cleanup services. With over 10 years of experience, our team follows industry standards to safely remove mold from residential and commercial properties across Toronto and the GTA.
We are fully certified by IICRC, CMR, and IAC2, and recognized by MICRO for professional mold remediation. As a WSIB-approved and BBB-accredited company, we ensure all mold removal work is completed using safe, compliant, and proven methods.
We handle mold removal in all areas of homes, including:
- Basement mold removal in Toronto homes with moisture and flooding issues
- Attic mold removal caused by poor ventilation and insulation problems
- Bathroom and kitchen mold from humidity and condensation
- Crawlspace and drywall mold contamination
- Black mold removal from walls, ceilings, and structural surfaces
Our mold removal services in Toronto address both the visible mold and the underlying moisture issues to ensure long-term results. Whether the mold is affecting drywall, wood, insulation, or concrete, we provide complete remediation solutions tailored to your property.

Call 647-985-2739 for WSIB & IICRC-CMRC Certified Professional Mold Removal & Testing in Toronto and the GTA.
Our Mold Removal Process
Step 1
Mold Inspection
Step 2
Mold Detection & Assessment
Step 3
Mold Removal & Containment
Step 4
Cleaning & Post-Remediation
Why Choose Us For Mold Removal in Toronto?
Choosing the right mold removal company in Toronto is critical to protecting your property and your health. At Ultimate Mold Crew, we combine certified expertise, proven mold remediation methods, and local experience to deliver safe and long-lasting results for homes and businesses across Toronto and the GTA.
- Certified Mold Removal Experts in Toronto: Our team is IICRC-certified with over 10 years of experience handling mold removal and remediation projects .
- Advanced Containment & HEPA Filtration: We use negative air pressure systems and HEPA filtration to safely remove mold and prevent cross-contamination during the remediation process.
- Complete Mold Remediation Solutions: We don’t just remove visible mold — we identify moisture sources and fix the root cause to prevent mold from returning.
- Compliant with Ontario Safety Standards: Our mold removal process follows Ontario Regulation 278/05 and ANSI/IICRC S520 guidelines for safe and compliant remediation.
- Detailed Documentation for Insurance: We provide full reports and documentation to support insurance claims and property records.
- Post-Remediation Verification: We conduct final testing to ensure your Toronto property is safe, clean, and ready for re-occupancy.
We follow ANSI/IICRC S520 procedures for mold cleanup and remediation guidelines from the IICRC, the NAMP, Ontario Association of Home Inspectors and the IAQA .
| Address | 11 Shallmar Blvd Unit 308, Toronto, ON M5N 1J6 Toronto, ON M5N 1J6 Canada |
| Certifications | IICRC, CMRC, IAC2 Certified, ECO Friendly |
| Accreditations | BBB Accredited, Google Guaranteed Business, Health Canada Mold Guide, Ontario Regulation 278/05 (Asbestos & Mold). |
| Awards | Top Rated Among Best Mold Removal Companies in GTA By HomeStars Canada |
We Serve All Neighbourhoods in Toronto – Brampton, Burlington, Halton Hills, Milton, Oakville, Downtown Toronto, West Toronto (Alderwood, Baby Point, Bloor West, High Park, Humber Bay, Islington, Junction, Kingsway, Lambton Mills, Long Branch, Mimico, New Toronto, Queensway, Roncesvalles, Summerville, Sunnylea, Swansea) Midtown, and The Beaches.
If you’re dealing with mold in your Toronto home or business, contact our team today for fast, reliable, and certified mold removal services.
24/7 Emergency mold removal Toronto [Open Now]
Call us at 647-985-2739 or send us an email at info@ultimatemoldcrew.ca.
Attic mold is a common issue in Toronto homes, often caused by poor ventilation, insulation problems, and trapped moisture. Because attics are rarely inspected, mold growth can go unnoticed until it spreads or is discovered during renovations or home inspections.
Our attic mold removal services in Toronto are designed to safely eliminate mold while addressing the root cause. We identify ventilation issues, correct moisture buildup, and ensure your attic remains mold-free long-term.
Removing attic mold is especially important when buying or selling a home in Toronto, as visible mold can reduce property value and delay transactions. Our team provides professional remediation and clearance documentation for peace of mind.
Call 647-985-2739 for professional attic mold removal in Toronto and the GTA, including North York, Scarborough, Etobicoke, and surrounding areas.
Why Is Professional Mold Remediation Important?
Mold growth is a common problem in Toronto homes, especially in basements, attics, crawlspaces, and areas affected by moisture. Without proper removal, mold can spread quickly and impact both your property and indoor air quality.
Hiring a professional mold removal company in Toronto ensures that mold is safely removed using proper containment, filtration, and remediation techniques. DIY or incomplete removal can lead to recurring mold problems and hidden contamination.
- Complete mold removal from affected areas, including hidden growth behind walls and ceilings
- Prevention of mold regrowth by addressing moisture sources
- Improved indoor air quality and healthier living conditions
- Protection of your property’s structure and long-term value
If you suspect mold in your home, book a professional mold inspection in Toronto to ensure your property is safe, clean, and mold-free..
Toronto Mold Removal FAQs
Attic - Mold growth due to poor ventilation or roof leaks
Bathroom - High humidity areas such as showers and baths
Basement - Prone to dampness and water intrusion
Windows and Doors - Mold around frames and window sills due to condensation
Cold Room/Cold Storage - High moisture levels in unheated spaces
Crawlspaces - Enclosed damp spaces under houses
Kitchen - Near sinks, drains, and appliances like fridges
Bedroom - Around windows, on carpet and furniture
Drywall - Absorbs moisture, supporting mold growth
Plaster - Older plaster walls may retain moisture
Ceiling - Water damage from leaks often leads to mold
Concrete - Mold in porous surfaces exposed to moisture
Foundation - Humidity and leaks can lead to mold in structural areas
Near Sinks and Drains - Constant moisture and organic material accumulation
Behind Appliances - Spaces behind washing machines and fridges often neglected
Common types of mold include black mold (Stachybotrys), green mold (Penicillium), and white mold. Prolonged mold exposure can lead to health issues such as respiratory problems and allergies. Preventing mold requires controlling moisture levels and ensuring proper ventilation.
Here are some critical statistics about mold you might not know.
⭐ Mold Statistics
⭐Mold Types: Over 100,000 mold species exist, with some posing significant health risks.
⭐Fungi Species: The CDC estimates that 500 different species of fungi are currently thought to be harmful to people.
Health Impact: Approximately 20% of individuals are sensitive to mold, leading to respiratory and allergic reactions.
⭐Home Invasion: Up to 50% of households have hidden mold issues, often unnoticed until health symptoms or structural damage appears.
⭐Moisture Connection: Mold growth can start within 24-48 hours in damp conditions, emphasizing the need for swift moisture control. – Fisk and Berkeley Laboratory colleagues found that dampness and mold exposures increase the occurrence of a range of respiratory problems by 30–50%. (Source: Ncbi.nlm.nih.gov )
According to a report published in the World Health Organization’s (WHO) journal The Lancet, 92% of the world’s population lives in places where air quality levels exceed WHO limits. (Source)
⭐ It is estimated that approximately 800,000 or 7 percent of the citizenry have been exposed to some extent and become sensitized to compounds present in poorly ventilated indoor air. (Source: Ncbi.nlm.nih.gov)
⭐Mold can be found in up to 9% of homes with a terrace, 26% of medical facilities like outpatient clinics and hospitals, and 18% of elementary to high school facilities. (Source: Ncbi.nlm.nih.gov )
⭐Each year, nearly 600,000 children under 5 years old die from the effects of air pollution.(Source: Berkley.edu)
⭐ According to a recent survey, 40% of homes in Canada. are affected by mold.
⭐20% of the population carries genes that make them more susceptible to mold-related health conditions, according to a study published in the journal Genome Biology.
⭐Researchers have found around 270 Species of Mold in Canada. (Source: pbs.org )
⭐ About 70% of Homes Have Mold.
⭐ Indoor mold and dampness are associated with an estimated $3.7 billion in annual health care costs for allergic rhinitis.
⭐ In Canada, Toronto, Ontario Tops the List of Most Allergy Patients with Mold and Mildew Sensitivities at 21%
⭐ Any kind of water damage (flood, pipe burst, leakage) can facilitate the growth of a mold in as soon as 24-48 hours. (Source: realtimelab.com/mold-statistics)
Sources – https://www.bustmold.com/resources/about-mold/types-of-mold/
- https://species.wikimedia.org/wiki/Fungi
- https://ultimatemoldcrew.ca/mold-issues/
- https://www.ncbi.nlm.nih.gov/pmc/articles/PMC1892134/
- https://www.who.int/data/gho/data/themes/air-pollution/who-air-quality-database/2022
- https://publichealth.berkeley.edu/news-media/research-highlights/new-research-shows-link-between-childhood-exposure-to-mold-and-asthma/
- https://www.pbs.org/newshour/science/the-sublime-slime-mold
- https://ultimatemoldcrew.ca/difference-between-mold-and-mildew/
- https://search.usa.gov/search?utf8=%E2%9C%93&affiliate=fema&query=mold&commit=Search+FEMA.gov
- https://www.niehs.nih.gov/health/topics/agents/mold
--- Allergenic: These species trigger allergies, sinus irritation, and asthma flare-ups. Sensitive individuals often react strongly, but even people without allergies can develop mild symptoms.
--- Pathogens: These molds mainly affect individuals with weakened immune systems or those recovering from serious illness.
--- Toxigenic:These strains produce dangerous mycotoxins and can cause health issues even in healthy adults.
Indoor mold growth is common in Toronto because of the city’s humidity cycles, older building stock, and basement moisture problems. Detecting and treating mold early prevents structural damage and reduces health risks, which is why trained mold remediation professionals are essential for accurate identification and safe removal. Lets know more about some common types of mold or fungi seen in household properties in Toronto, GTA areas.
--- Aspergillus
This species appears frequently in Toronto homes, especially in kitchens, bathrooms, and air conditioning systems. With more than one hundred and eighty known strains, Aspergillus can show different colours and textures.
Most strains are harmless, but some can cause respiratory illness or lead to aspergillosis in individuals with weaker immune systems. Because visual identification is unreliable, testing is recommended whenever Aspergillus is suspected.
--- Cladosporium
Cladosporium often grows as black or dark green pepper-like dots on bathroom surfaces, painted walls, and fiberglass air ducts.
It spreads quickly in damp indoor environments and is a common trigger for allergy and asthma symptoms.
--- Fusarium:
Appearance: Pink or reddish stains
Habitat: Carpet, upholstery, wallpaper, draperies
Temperature behaviour: Continues to grow in near-freezing conditions
Prevention: Routine vacuuming with a HEPA-grade vacuum reduces spread
Fusarium spreads fast in homes with chronic moisture issues, especially older Toronto basements and cold storage areas.
--- Penicillium:
Allergenic and pathogenic: yes
Symptoms: sinusitis, difficulty breathing, asthma episodes, chronic health problems in people with immune system disorders
Appearance: bluish-green fluffy mold
Habitat: homes with flooding or water damage, constant humidity required
Treatment: professional mold treatment recommended
--- Trichoderma:
Appearance: Small raised white spots, green mold in damp areas
Habitat: damp places like near leaky windows or around showers
Growth: quick in damp places
Symptoms: coughing, sneezing, bronchial infections
Mold [Ref: cdc.gov] that appears to be orange or red in color is typically found outdoors, given its nature to thrive on decaying plants or moist wood. This type of mold, can appear slimy, is harmless and should only be removed for aesthetic purposes.
There are many types of mold that look black, and not all “black mold” are as toxic as Stachybotrys.
SOURCES:
-- https://en.wikipedia.org/wiki/Spore#Fungi
-- https://commons.wikimedia.org/wiki/Mold
-- https://www.cdc.gov/mold-health/about/index.html#cdc_environmental_basics_types-common-types
-- https://pmc.ncbi.nlm.nih.gov/articles/PMC5490296/
-- https://en.wikipedia.org/wiki/Cladosporium
-- https://en.wikipedia.org/wiki/Fusarium
-- https://ultimatemoldcrew.ca/pink-mold-shower/
-- https://www.britannica.com/science/Penicillium
-- https://ultimatemoldcrew.ca/blue-mold-on-walls-ceiling-home/
-- https://ultimatemoldcrew.ca/white-mold-types-causes-removal/
-- https://ultimatemoldcrew.ca/green-mold-dangerous/
-- https://www.cdc.gov/mold-health/about/index.html
-- https://ultimatemoldcrew.ca/orange-slime-mold/
-- https://en.wikipedia.org/wiki/Black_mold
-- https://www.cdc.gov/mold/stachy.htm
Improve the airflow at your house to warrant that there is proper ventilation.
Ensure all household surfaces are clean and dry at all times to reduce chances of mold to grow.
Similarly, if there are any leaks, repair them on time and monitor your rooms and spaces regularly.
Take measures against having a damp environment at home.
Common Short-Term Reactions to Mold
• Sneezing
• Itchy or watery eyes
• Nasal congestion
• Headaches
• Coughing
• Asthma flare-ups
These symptoms appear in many Toronto homes during winter when buildings stay closed and air circulation drops.
Additional Symptoms Linked to Mold Exposure
Some individuals experience broader health effects such as:
• Nausea
• Fatigue
• Vomiting
• Diarrhea
• Skin irritation
• Memory difficulty
• Breathing trouble
• Immune system stress
Ask yourself:
Do symptoms ease when you leave a certain room?
Do you feel better while at work or outdoors?
Do symptoms return within minutes of re-entering your home?
If the pattern repeats, hidden mold could be the cause. Quick mold remediation helps restore indoor air quality and reduces ongoing health problems.
Mold Publications
--Chew GL, Horner WE, Kennedy K, Grimes C, Barnes CS, Phipatanakul W, Larenas-Linnemann D, Miller JD, Environmental Allergens Workgroup. “Procedures to assist healthcare providers to determine when home assessments for potential mold exposure are warranted.” J Allergy Clin Immunol Pract 2016; 4:417-22. DOI: 10.1016/j.jaip.2016.01.013.
--Major JL, Boese GW. “Cross Section of Legislative Approaches to Reducing Indoor Dampness and Mold.” J Public Health Management & Practice 2017; 23 (4): 388–395. DOI: 10.1097/PHH.0000000000000491.
--Damon SA, Chew GL. “Mold Cleanup Practices Vary by Sociodemographic and Allergy Factors.” Journal of Environmental Health 2020.
--https://doi.org/10.1016/j.jaip.2016.01.013
--https://doi.org/10.1097/PHH.0000000000000491
--https://www.ncbi.nlm.nih.gov/pmc/articles/PMC8978808/
1. Inspect for Visible Signs
Look for discoloured patches on drywall, wood, fabrics, or basement floors.
Household mold may appear black, green, white, red, or even blue.
Textures can vary: fuzzy, slimy, furry, or slick.
👉 Tip: Visible mold often indicates a deeper, hidden problem.
2. Monitor Health Symptoms
Mold spores can trigger allergies, coughing, watery eyes, and nasal irritation.
Unexplained illness indoors may be a warning sign.
Persistent musty odours also point to hidden mold growth.
3. Test Indoor Air Quality
Professional and DIY air quality tests can detect spore levels.
Airborne mold spores lodge in the respiratory system, making early detection important.
Regular testing ensures your home maintains safe air quality.
4. Scrub and Clean Surfaces
Use soap, water, and a stiff brush on affected areas.
Scrub deeply to reach porous surfaces like wood and drywall.
Disinfect after scrubbing to minimize regrowth.
5. Control Moisture & Humidity
Mold thrives where moisture is present.
Use hygrometers to keep humidity below 50%.
Pay special attention to basements, bathrooms, attics, and cold rooms.
6. Know When to Call a Professional
If mold covers more than 10 square feet, or keeps returning, call a certified mold removal expert.
Professionals use advanced tools (infrared cameras, air pumps, moisture meters) and provide detailed remediation plans.
A professional air quality test is the most reliable way to confirm if mold still exists.
✅ Key Takeaway: Small mold patches can be cleaned at home, but recurring or widespread mold requires professional inspection and removal to protect both your property and health.
References :
- https://www.canada.ca/en/health-canada/services/publications/healthy-living/residential-indoor-air-quality-guideline-moulds.html
- https://citeseerx.ist.psu.edu/viewdoc/download?doi=10.1.1.664.3855&rep=rep1&type=pdf
- https://www.niehs.nih.gov/health/topics/agents/mold/index.cfm
- https://www.thecanadianencyclopedia.ca/en/article/mold
Reach Us On Google Maps
Mold Knowledgebase
Explore our blog for detailed mold checklists, DIY tips, guides, and infographics on mould prevention to maintain a healthy home. Get practical solutions with expert advice to kill mold effectively.